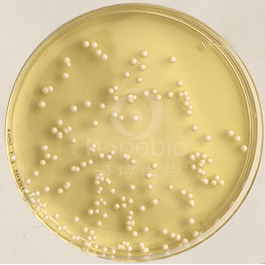

用途:用于化妆品中白色念珠菌分离培养。
氯霉素的作用:
氯霉素对革兰氏阳性、阴性细菌均有抑制作用且对后者的作用较强。常用于真菌的选择性分离,抑菌细菌的生长发育。
用法
Suspend 65.05g/liter,autoclave (15min at 121℃).
称取本品 65.05g,加热搅拌溶解于 1000ml 蒸馏水中,121℃高压灭菌 15 分钟,冷却至 50-55℃时,倾入无菌平皿 。
不同细菌在沙氏葡萄糖氯霉素琼脂(ISO标准)上的生长特征:
|
|

|
|

|
|
白色念珠菌
白色圆形凸起
|
|
黑曲霉菌
有黑色孢子
|
|
大肠埃希氏菌
抑制
|
沙氏葡萄糖氯霉素琼脂(ISO标准)微生物灵敏度试验:
按标签用法制备培养基,接种以下质控菌株,放置20-25℃需氧培养48-72小时。
注:回收率计算时,用SDA琼脂做对照培养基。